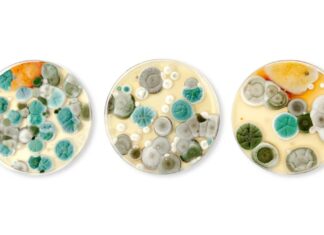
Identificando fungos internos comuns: um guia para prevenção e riscos à saúde

Maintaining a garden shouldn’t feel like a chore. For years, many gardeners have struggled with the frustration of tangled lines and the physical strain of manually coiling heavy hoses. To solve this, we tested over 34 different hose reels to identify which models actually improve your gardening experience.
When choosing a reel, the “best” option depends on your specific needs: do you need to transport a long hose across a large lawn, or are you looking for a discreet, wall-mounted solution to save space? Our testing focused on durability, ease of use, and setup simplicity to help you find the perfect upgrade.
🏆 Top Recommendations at a Glance
| Category | Model | Key Feature | Type |
|---|---|---|---|
| Best Overall | Gorilla Mobile Hose Reel | Durable aluminum & easy maneuverability | Cart (2 wheels) |
| Best Retractable | Giraffe Tools Retractable | Automatic retraction & space-saving | Wall-mounted |
| Best Cart | Style Selections Steel | High capacity (250 ft) & rugged build | Cart (4 wheels) |
| Best Hideaway | Giraffe Metal Box | Stylish, weather-resistant enclosure | Hideaway |
| Best Wall-Mounted | Liberty Garden Decorative | Aesthetic design with storage shelf | Wall-mounted |
| Best Budget | Artigarden Freestanding | Simple, no-assembly stake design | Hanger |
| Most Versatile | Flexzilla Retractable | Can be freestanding or wall-mounted | Retractable |
🥇 The Top Performers: Detailed Analysis
Best Overall: Gorilla Mobile Hose Reel
If you want a balance of durability and ease of movement, the Gorilla Aluminum Hose Reel is the standout winner. Its aluminum frame is built to last, and the “flat-free” rubber wheels ensure you won’t be stuck dealing with maintenance mid-season.
- Pros: Easy to maneuver on various surfaces; comfortable rubber grips; includes a generous 6-foot leader hose.
- Cons: Assembly can be slightly tedious due to screw placement; handle height may be short for very tall users.
- Ideal For: Gardeners who need to move their water source frequently across different terrains.
Best Retractable: Giraffe Tools Retractable Garden Hose Reel
For those prioritizing convenience and tidiness, this wall-mounted unit is a game-changer. It allows you to pull out exactly the length you need and retracts smoothly when finished.
- Pros: Includes a 130-foot hose and nozzle; saves significant space; easy to use once mastered.
- Cons: Installation instructions for concrete walls are lacking; requires a slight learning curve to lock the hose.
- Ideal For: Small gardens or urban spaces where keeping equipment organized is a priority.
Best Heavy-Duty Cart: Style Selections Steel 250-ft Cart Reel
This is the workhorse of the group. Designed to handle massive amounts of hose (up to 250 feet), this four-wheeled cart is built for ruggedness.
- Pros: Extremely durable (weather-tested through rain and snow); includes a storage basket for tools; easy to push over bumps.
- Cons: Lacks a brake or stability legs; requires monitoring to prevent hose kinking during winding.
- Ideal For: Large properties with long hoses and uneven ground.
Best Aesthetic Hideaway: Giraffe Metal Hose Reel Box
Not all garden equipment needs to look industrial. The Giraffe Metal Box offers a sophisticated, bronze-colored design that protects your hose from the elements while looking great in a yard.
- Pros: Features a threading guide to ensure even winding; highly weather-resistant; much more stylish than plastic alternatives.
- Cons: Not a rolling model (must be lifted); requires manual winding.
- Ideal For: Homeowners who want to protect their hose from UV damage while maintaining curb appeal.
Best Decorative Wall-Mount: Liberty Garden Decorative Reel
This model combines functionality with charm. It is a sturdy, wall-mounted steel reel that also features a convenient top shelf for nozzles and small hand tools.
- Pros: Very stable once mounted; smooth winding action; includes a helpful storage tray.
- Cons: Does not include mounting hardware or detailed installation instructions.
- Ideal For: Adding a touch of style to a patio or deck while keeping tools within reach.
Best Budget Option: Artigarden Freestanding Hanger
If you want something simple and inexpensive, this metal stake is the way to go. It requires zero assembly—just stake it into the ground.
- Pros: Very affordable; lightweight and easy to reposition; extremely simple design.
- Cons: You must wind the hose manually; may tip over in very loose or saturated soil.
- Ideal For: Vegetable garden beds where a quick, low-cost storage solution is needed.
Most Versatile: Flexzilla Retractable Water Hose Reel
The Flexzilla offers the ultimate flexibility: you can use it as a freestanding unit or mount it to a wall. It comes fully assembled with a high-quality 70-foot hose included.
- Pros: Two modes (free-run or latching); includes all necessary mounting hardware; highly portable.
- Cons: Can be tricky to lock the hose into place; requires wall mounting for maximum stability.
- Ideal For: Users who want the benefits of a retractable system without committing to a permanent wall installation.
💡 Summary & Final Verdict
Choosing the right hose reel comes down to a trade-off between portability and automation. If you want to move around your yard easily, choose a cart-style reel like the Gorilla. If you want to minimize effort and maximize space, a retractable wall-mounted model from Giraffe Tools is your best bet.
Expert Tip: Always consider your terrain. If your garden has hills or gravel, prioritize models with “flat-free” rubber wheels to avoid the frustration of a flat tire mid-watering.